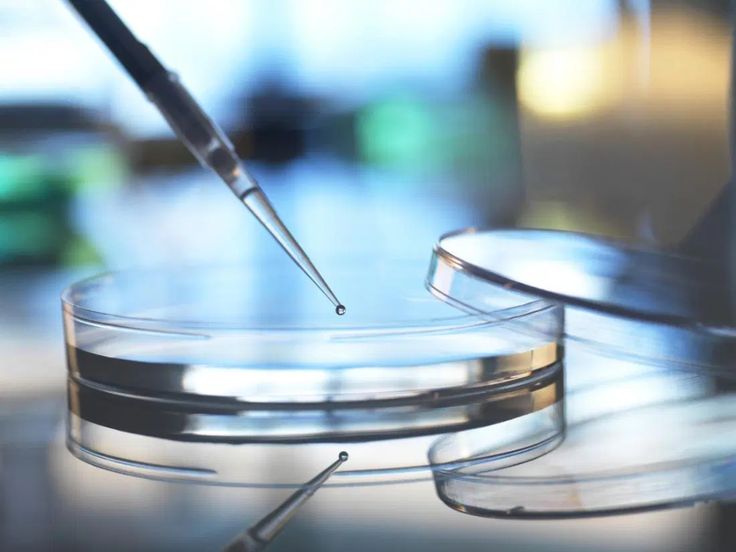
Medical Tourism to Mexico: Stem Cell Therapy

Tabla de contenido
Are you considering medical tourism to Mexico? If so, you’re not alone. Every year, thousands of individuals travel south of the border for innovative healthcare solutions that may be more affordable and accessible than what’s offered at home.
As we delve into this topic, we’ll uncover everything you need to know about stem cell therapy in Mexico—from the types of treatments available to cost considerations and safety measures. Make sure your journey toward better health starts on the right foot!
Stem Cells Treatment México
Stem cell treatment in Mexico has gained significant popularity over recent years. This growing interest is largely due to the advancements in regenerative medicine, which offer new hope for patients dealing with chronic illnesses and injuries.
Mexican clinics are equipped with cutting-edge technology and highly trained professionals who specialize in stem cell therapies.
One aspect that sets Mexico apart is its regulatory environment surrounding stem cell research and treatment. While some countries impose strict limitations on such procedures, many Mexican facilities operate under more flexible guidelines that support innovative practices.
Patients can also benefit from a more personalized approach when seeking care abroad. Many clinics provide tailored treatment plans based on individual needs, ensuring that each person receives attention suited to their specific condition.
Core Treatment Overviews
Stem cell therapy is a revolutionary approach that harnesses the human body’s natural healing capabilities. It involves using stem cells to repair or regenerate damaged tissues and organs. This treatment has shown promise for various conditions, including degenerative diseases, injuries, and chronic pain.
One popular application of stem cell therapy in Mexico is for orthopedic issues. Patients suffering from arthritis or joint injuries can benefit significantly from this innovative treatment. Stem cells can help reduce inflammation, promote tissue regeneration, and enhance mobility.

In addition to orthopedics, stem cell therapy is making strides in neurology. Conditions like multiple sclerosis and Parkinson’s disease are being explored through clinical trials focused on cellular treatments.
Cardiovascular health also sees advancements with stem cell applications aimed at repairing heart damage after events like myocardial infarction (heart attack).
For those grappling with autoimmune disorders such as lupus or rheumatoid arthritis, medical tourism to Mexico provides access to cutting-edge therapies that are not always available elsewhere.
Cost and Accessibility
When considering medical tourism to Mexico, cost plays a significant role. Stem cell therapy in Mexico is often substantially more affordable than in the United States or Canada. Many patients find that they save thousands of dollars while still receiving high-quality care.
Prices can vary depending on the clinic and specific treatment required. On average, stem cell procedures might range from $5,000 to $20,000. This is a fraction of what similar treatments would cost in North America or Europe.

Accessibility is another advantage of seeking stem cell therapy in Mexico. Many clinics are located near popular tourist destinations like Cancun and Tijuana, making travel convenient for international patients.
Language barriers are also less daunting nowadays; many healthcare professionals speak English fluently and provide comprehensive support throughout your stay.
Safety and Clinic Selection
When considering medical tourism to Mexico for stem cell therapy, safety and clinic selection are paramount. The landscape of healthcare in Mexico has evolved significantly. Many clinics offer advanced treatments under rigorous standards.
Start by researching the clinic’s credentials. Look for facilities accredited by recognized organizations such as the Joint Commission International (JCI).

Patient reviews can provide valuable insights into a clinic’s reputation and service quality. Seek testimonials from previous patients who underwent similar procedures. Their experiences can guide your decision-making process.
Additionally, consult with healthcare professionals who specialize in stem cell therapy before making any commitments. They can help clarify treatment protocols and expected outcomes, ensuring you make informed choices about where to go.
FAQs | Medical Tourism to Mexico: Stem Cell Therapy
Is Stem Cell Therapy Safe and Legal in Mexico?
Stem cell therapy is safe and legal in Mexico when performed at clinics certified by COFEPRIS, Mexico’s health regulatory body, with reported success rates around 83%. Reputable facilities adhere to international standards like ISO and require ethical cell sourcing.
What Conditions Can Stem Cell Therapy Treat?
Therapy targets conditions like osteoarthritis, chronic pain, joint issues, neurological disorders, and autoimmune diseases. It promotes tissue regeneration, such as cartilage and bone repair, improving mobility and reducing pain. Eligibility requires a medical assessment based on health history, blood tests, and scans.
What Is the Treatment Process for Medical Tourists?
The process spans 3-4 days: Day 1 for consultation, Day 2 for pre-tests like blood work and imaging, Day 3 for stem cell administration via injections or infusions, and Day 4 for follow-ups. Clinics in hubs like Guadalajara or Los Algodones provide personalized care, including transport and translation support. Pre-arrival screening involves submitting health reports for eligibility.
